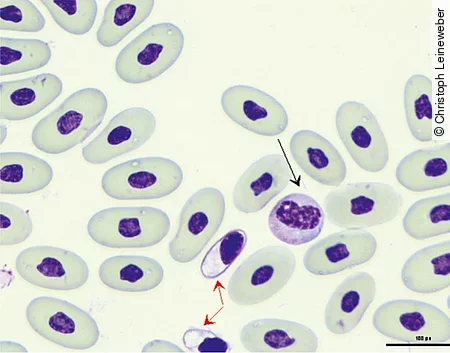
Im Blutausstrich einer Boa constrictor sieht man einen Azurophilen und einen Thrombozyt.

Inhalt

Eine Vielzahl verschiedener Schlangenarten wird in privaten Haushalten gehalten. Am beliebtesten sind Nattern, zum Beispiel Kornnattern sowie diverse Pythons und Boas. Gründe für eine Vorstellung in der tierärztlichen Praxis sind neben der Abklärung von Erkrankungen auch zunehmend Routinechecks und die Untersuchung von neu zugekauften Tieren. Teil dieser Untersuchung ist häufig eine Blutanalyse.
Wo entnehme ich das Blut?
V. coccygealis ventralis
Aufgrund der Anatomie der Tiere sind die Entnahmemöglichkeiten bei Schlangen begrenzt. Die häufigste und sicherste Methode für eine Blutentnahme stellt die ventrale Schwanzvene, V. coccygealis ventralis [Abb. 1], dar. Diese wird im Bereich von 25–50 % der Schwanzlänge distal der Kloake punktiert. Ein gewisser Abstand zur Kloake ist wichtig, damit die Hemipenestaschen, die in unterschiedlicher Ausprägung bei beiden Geschlechtern vorhanden sind, nicht punktiert werden. Zur Blutentnahme wird die Kanüle medial angesetzt und im 45–60° Winkel kraniodorsal Richtung Wirbelsäule eingestochen.

Bei der Entnahme an der ventralen Schwanzvene kann es zu einer Kontamination des Blutes mit Lymphe kommen. Diese kann zu einer Verfälschung diverser Laborparameter führen, was eine sichere Diagnostik erschwert. Proben, die bei der Entnahme offensichtlich mit Lymphe verdünnt sind, sollten – falls möglich – neu genommen werden. Andernfalls müssen die Ergebnisse der Blutuntersuchung entsprechend interpretiert werden.
Herz
Eine weitere Möglichkeit, gerade für größere Blutentnahmemengen, ist die Punktion des Herzens [Abb. 2]. Das Herz befindet sich im Bereich von 22–33 % der Körperlänge und kann entweder durch Beobachtung des Herzschlags durch die Bauchdecke hindurch oder auch durch Ultraschall genau lokalisiert werden. Auch hier erfolgt die Punktion wieder medial im 45° Winkel nach kraniodorsal.

Cave
Bei der Punktion des Herzens kann es schnell zu Verletzungen des Herzbeutels und so zu größeren, wenig kontrollierbaren Blutungen kommen.
Um ein starkes Nachbluten zu verhindern, sollte die Punktionsstelle nach Herausziehen der Kanüle 1 Minute manuell komprimiert werden. Eine Herzpunktion sollte nur von erfahrenen Tierärzt*innen durchgeführt werden.
V. palatina pterygoidia
Eine andere in der Literatur beschriebene Möglichkeit stellt die Punktion der V. palatina pterygoidia im Maul dar. Diese ist bei großen Schlangen im dorsalen Maulbereich zwar gut zu sehen, aber nicht einfach zu punktieren. Es kommt oft zur Bildung großer Hämatome.
Wie viel Blut darf ich entnehmen?
Bei Schlangen entsprechen etwa 5–8 % des Körpergewichts dem Blutvolumen der Tiere, wovon 10 % entnommen werden können, ohne dass die Tiere dadurch beeinträchtigt werden. Als Faustregel für die maximale Entnahmemenge gilt, dass höchstens 0,7 ml pro 100 g Körpergewicht pro Blutentnahme entnommen werden dürfen, wobei auch der klinische Zustand des Patienten berücksichtigt werden muss. Stark geschwächte oder dehydrierte Tiere sollten erst einmal durch Infusionen stabilisiert werden.
Was schicke ich ins Labor?
Die Wahl der Antikoagulanzien ist entscheidend für die spätere Messbarkeit und Aussagekraft der Laborparameter. Im Unterschied zu Schildkröten führt EDTA bei Schlangen in der Regel nicht zu einer Hämolyse, wodurch man die Wahl hat, ob man EDTA- oder Lithium-Heparin-Vollblut für eine hämatologische Untersuchung benutzt. In der Literatur ist beschrieben, dass Lithium-Heparin häufiger eine Aggregatbildung bei den Thrombozyten und auch bei den Leukozyten bewirkt. Das kann dazu führen, dass die Anzahl und Morphologie dieser Zellen nicht optimal beurteilt werden können. Lithium-Heparin-Plasma kann aber noch für die Bestimmung der klinisch-chemischen Parameter genutzt werden, denn im Gegensatz zu EDTA-Plasma können hieraus auch die alkalische Phosphatase, Kalzium und Kalium bestimmt werden. Besonders bei kleinen Tieren, bei denen man nur wenig Blut gewinnen kann, hat man bei Lithium-Heparin den Vorteil, dass man sowohl ein Blutbild als auch die klinisch-chemischen Parameter bestimmen kann.
Um einen optimalen Zellerhalt für die hämatologische Untersuchung zu gewährleisten, ist es von Vorteil, direkt im Anschluss an die Blutentnahme einen ungefärbten Blutausstrich anzufertigen und diesen luftzutrocknen. Da Blutzellen sehr empfindlich sind und bei längerem Transport und ungünstigen Lagerungstemperaturen schnell degenerieren, erhöht man dadurch die Aussagekraft des Differenzialblutbilds. Zudem besteht nicht mehr die Gefahr, dass ein Blutbild aufgrund von Gerinnselbildung während des Transports unmöglich wird. Der fertige Ausstrich kann, nachdem er luftgetrocknet ist, ungefärbt ins Labor geschickt werden.
Das beste Material für eine klinisch-chemische Untersuchung ist Lithium-Heparin-Plasma. Wird die Probe nicht abzentrifugiert und abpipettiert, kann es durch längere Lagerung zu einer Hämolyse kommen. Dies führt zum Anstieg des Kaliumspiegels und zur Freisetzung von Hämoglobin, wodurch eine photometrische Messung der klinisch-chemischen Parameter beeinträchtigt werden kann. Zu beachten ist, dass es auch bei abzentrifugiertem Serum nachträglich bei der Lagerung oder während des Transports zum Labor noch zu einer Gerinnselbildung kommen kann, da die Gerinnung bei Reptilien zum Teil stark verzögert ist.
Kurz notiert
Für eine hämatologische und klinisch-chemische Untersuchung werden möglichst abzentrifugiertes Lithium-Heparin-Plasma sowie Lithium-Heparin oder EDTA-Vollblut und ein ungefärbter Blutausstrich eingeschickt [Abb. 3].

Welche diagnostischen Aussagen ermöglichen eine hämatologische Untersuchung?
Die hämatologische Untersuchung kann wichtige Informationen im Hinblick auf Entzündungen liefern. Der Hämatokrit kann aber auch Hinweise auf eine Anämie oder Dehydration liefern.
Ein sehr niedriger Hämatokrit kann auch durch eine Verdünnung der Blutprobe mit Lymphe bedingt sein.
Da bei Reptilien alle Blutzellen kernhaltig sind, besteht nicht wie beim Säuger die Möglichkeit, die Leukozyten automatisiert zu bestimmen. Die Bestimmung des Hämatokrits erfolgt nach der Mikrohämatokrit-Methode. Eine Zählung und Differenzierung der Leukozyten erfolgt in der Regel am Blutausstrich, der mittels Diff-Quick oder Wright-Giemsa gefärbt wird.
Die Erythrozyten sind bei Reptilien größer als bei Säugern und haben einen zentralen, ovalen Kern. Artefakte, die wie Einschlüsse aussehen, kommen häufiger vor und beruhen zum Teil auf Trocknungsartefakten. Diese dürfen nicht mit Einschlüssen verwechselt werden, die durch bakterielle, virale oder parasitäre Infektionen verursacht wurden.
Wie die Erythrozyten sind auch die Thrombozyten kernhaltig. Ihre Form variiert sehr stark, sodass sie bei schlechtem Zellerhalt schnell mit Lymphozyten verwechselt werden können. Häufig werden auch Thrombozytenaggregate im Blutausstrich beobachtet [Abb. 4].

Die Leukozyten lassen sich in 2 große Gruppen differenzieren:
- mononukleäre Leukozyten (Lymphozyten und Monozyten)
- Granulozyten
Lymphozyten [Abb. 5] und Monozyten ähneln denen der Säuger. Bei Schlangen findet man sehr häufig die sogenannten Azurophilen [Abb. 6]. Diese werden zu den Monozyten gezählt, sind etwas kleiner und haben einen runden bis ovalen unsegmentierten Kern. Das basophile Zytoplasma ist dunkler als bei Monozyten und stellt sich blau bis lavendelfarben dar.

Man unterscheidet heterophile, eosinophile und basophile Granulozyten. Die heterophilen Granulozyten stellen sich bei Schlangen als runde Zellen mit farblosem Zytoplasma und spindelförmigen, orangefarbenen Granula dar, die etwas verblasst und verschwommen aussehen. Der Kern der Heterophilen ist rund bis oval und liegt eher am Rand [Abb. 7]. Eosinophile sind durch runde, orangefarbene Granula, bläuliches Zytoplasma und einen meist zentralen, zum Teil aber auch randständigen Kern gekennzeichnet. In der Klasse der Reptilien besitzen Schlangen die größten Eosinophilen. Basophile sind kleiner und durch dunkelblaue- bis lilafarbene Granula gekennzeichnet, die sich oft über dem Kern anordnen und ihn im mikroskopischen Bild verdecken. Sie sind jedoch relativ selten im Blutausstrich zu finden. Reaktives Verhalten der Leukozyten führt häufig zu runden lila bis blauen Einschlüssen in den Zellen, die dann als zytotoxische Einschlüsse angesprochen werden können.

Spezies, Geschlecht, Alter, physiologischer Zustand des Tieres und die Jahreszeit beeinflussen die Anzahl und das Verhältnis der verschiedenen Leukozyten. Veränderungen in der Morphologie der einzelnen Zellen können jedoch Hinweise auf Infektionen geben. Verschiebungen in der Zellzahl fallen bei Reptilien geringer aus als bei Säugern und sind daher schwieriger zu interpretieren. Aber auch hier können bakterielle und parasitäre Infektionen sowie Stress zu einem Anstieg der Heterophilen führen. Die Eosinophilen sind bei parasitären Infektionen und einer Stimulation des Immunsystems erhöht. Erhöhte Lymphozytenzahlen kommen bei Wundheilung, Entzündungen sowie parasitären und viralen Infektionen vor.
Welche klinisch-chemischen Parameter sind bei Schlangen besonders wichtig?
Auch bei den klinisch-chemischen Parametern kann es abhängig von Spezies, Geschlecht, Jahreszeit und Temperatur zu Veränderungen der einzelnen Parameter kommen. Die Beimengung von Lymphe führt zu erniedrigten Protein- und Kaliumwerten. Traumata bei der Blutentnahme, zum Beispiel durch mehrfach missglückte Venenpunktion, können zu einer Erhöhung der alkalischen Phosphatase (AP) und der Kreatinkinase (CK) führen.
Besserer Vergleich
Aufgrund der starken Variation der Normalwerte bei einigen Spezies empfiehlt es sich, Blutuntersuchungen auch bei gesunden Tieren durchzuführen, um die Ergebnisse im Krankheitsfall besser vergleichen und interpretieren zu können.
Nierenwerte
Als wichtigstes Endprodukt des Protein- und Purinstoffwechsels bei terrestrischen Arten dient die Harnsäure auch als der wichtigste Indikator für Nierenerkrankungen.
Starke Erhöhungen kommen bei folgenden Erkrankungen vor:
- diverse Nierenerkrankungen
- Gicht
- Nierenfunktionsstörungen durch Bakteriämie und Septikämie
- Nierennekrosen durch nephrotoxische Medikamente wie Aminoglykoside und Sulfonamide
Da sich Schlangen karnivor ernähren, ist es wichtig zu beachten, dass sie physiologisch etwas höhere Harnsäurewerte im Blut aufweisen als herbivore Reptilien. Außerdem kommt es circa 1 Tag nach der Nahrungsaufnahme zu einem Anstieg des Harnsäurespiegels um das 1,5- bis 2-Fache.
Bitte nicht füttern
Um Fehlinterpretationen zu vermeiden, sollten die Tiere vor der Blutentnahme nicht gefüttert werden, um möglichst nüchtern zu sein.
Erniedrigte Harnsäurewerte kommen im Zusammenhang mit Lebererkrankungen vor. Bei Nierenerkrankungen kommt es auch zum Anstieg des Phosphatgehalts im Blut. Eine Hyperphosphatämie kann jedoch auch durch exzessive Zufuhr mit der Nahrung, Hypervitaminose D und Hämolyse bedingt sein. Bei Jungtieren ist der Phosphatgehalt durch das Knochenwachstum physiologisch erhöht.
Leberwerte
Als Indikator für Leberzellschäden dient die GLDH (Glutamatdehydrogenase). Diese kommt in den Mitochondrien der Leberzellen vor und wird erst durch Zerstörung der Zellen ins Blut freigesetzt. Weitere Enzyme, die in der Leber gefunden werden, sind die ALT (Alanin-Aminotransferase), die AP (alkalische Phosphatase) und die AST (Aspartat-Aminotransferase). Diese Enzyme kommen jedoch nicht nur in der Leber, sondern auch in anderen Organen des Körpers vor, sodass sie nicht spezifisch sind und im Zusammenhang mit anderen Blutwerten und physiologischen Zuständen interpretiert werden müssen. Zum Beispiel kommt die AST auch in den Muskelzellen vor, daher erfolgt eine Beurteilung immer im Zusammenhang mit dem CK-Wert, da CK nur in der Muskulatur vorkommt. Durch den Vergleich bekommt man Hinweise darauf, ob eine Erhöhung muskulären oder hepatogenen Ursprungs ist.
Als Leberfunktionsparameter dienen Stoffe, die natürlicherweise von der Leber synthetisiert werden und bei einer Störung der Leberfunktion erniedrigt oder erhöht sind. In diesem Zusammenhang ist vor allem die Gallensäure zu nennen. Diese kann jedoch auch durch die Fütterung, eine Verlegung der Gallengänge und Dehydration verändert sein. Ein weiterer Funktionsparameter sind die Eiweißfraktionen im Blut, die jedoch auch durch die Nahrungsaufnahme und die Nierenfunktion beeinflusst werden. Bilirubin wird bei den meisten Reptilien nicht gebildet, da das Enzym zum Umbau aus Biliverdin fehlt, wodurch dieser Parameter nicht zur Überprüfung der Leberfunktion herangezogen werden kann.
Besonders bei Riesenschlangen kommt es häufiger durch Überernährung und mangelnde Bewegung aufgrund des begrenzten Platzangebots oder mangelnder Bewegungsanreize zu einer Leberzellverfettung, die sich durch veränderte Leberwerte, aber auch durch Erhöhung des Triglyzerid- und Cholesterinspiegels im Blut äußert. Zu beachten ist jedoch, dass diese Parameter bei Weibchen während der Eianbildung (Vitelogenese) physiologisch erhöht sind.
Welche Infektionen werden durch Blutuntersuchungen diagnostiziert?
Blut kann auch als Probenmaterial für die Diagnose von einigen wichtigen Infektionserregern bei Schlangen dienen. Hierbei sollte zwischen direktem Erregernachweis im Blut, zum Beispiel bei Blutparasiten, Bakteriämien, Septikämien oder einigen Viren und dem Nachweis von Antikörpern unterschieden werden. Beim Neukauf von Tieren kann die Blutuntersuchung eine besondere Bedeutung haben.
Blutparasiten
Blutparasiten spielen besonders bei importierten Wildfängen eine Rolle und können im Blutausstrich nachgewiesen werden. Am häufigsten finden sich Hemogregarinen. Klinisch zeigen infizierte Tiere oft keine Symptome, sodass die Diagnose oftmals einen Zufallsbefund darstellt. Diese Parasiten durchlaufen einen sexuellen und einen asexuellen Zyklus, wobei der sexuelle Zyklus immer im Invertebraten stattfindet. Die Übertragung erfolgt durch Blut oder das Fressen eines infizierten Insekts. Im Blutausstrich findet man die Gametozyten meist als längsovale Gebilde in den Erythrozyten.
Viren
Arenaviren
Eine bei Riesenschlangen weltweit sehr verbreitete virale Erkrankung ist die „Inclusion Body Disease“ (IBD). Diese durch Arenaviren verursachte Erkrankung führt bei Boas und Pythons häufig zu neurologischen Störungen wie Kopftremor, Opisthotonus und Verlust des Umdrehreflexes sowie zu einer Schwächung des Immunsystems. Die Erkrankung kann mit chronischer Abmagerung, Erbrechen, Stomatitis, Dermatitis und respiratorischen Störungen assoziiert sein. Die Übertragung erfolgt horizontal, aber auch vertikal. Der Nachweis der Arenaviren erfolgt mittels PCR aus EDTA-Blut, Rachenabstrichen oder Biopsien, v.a. der Leber oder der ösophagealen Tonsillen. Zum Teil können die Einschlusskörperchen [Abb. 8] auch im Blutausstrich sowie in Biopsien nachgewiesen werden. Der Nachweis von Viren und Einschlüssen erfolgt bei Pythons deutlich seltener als bei Boas. In einigen Fällen ist dies auch nur durch eine Untersuchung des Gehirns möglich.

Es sind noch eine Reihe anderer Viren bei Schlangen beschrieben, die aber derzeit nicht mittels Blutuntersuchung diagnostiziert werden können.
Antikörpernachweis
Bei dem serologischen Nachweis von Antikörpern gegen Krankheitserreger ist zu beachten, dass der Antikörpernachweis nicht unbedingt etwas über den jetzigen Infektionsstatus des Tieres aussagt. Das Immunsystem der Reptilien ist auch besonders stark von der Umwelt, zum Beispiel Temperatur und Jahreszeit, abhängig. Zudem kann die Zeit zwischen Infektion und Bildung nachweisbarer Antikörper länger sein als bei Säugetieren.
Wichtige virale Erreger, bei denen die Serologie häufig eingesetzt wird, sind Paramyxoviren (Genus Ferlavirus). Ferlaviren treten besonders bei Vipern und Nattern, aber auch bei anderen Schlangen auf. Sie befallen vorrangig den Respirationstrakt, was bei den Tieren zu Atemgeräuschen, Maulatmung und vermehrtem Schleim in Nase und Maulhöhle führt. Direkte Virusnachweise aus Lungenspülproben und Rachen- und Kloakentupfer mittels PCR sind möglich.
Fazit
Zusammenfassend kann man sagen, dass die Blutuntersuchung eine gute Möglichkeit bietet, um einen Überblick über den Gesundheitszustand des Patienten zu bekommen und Diagnosen aus der klinischen Untersuchung bestätigen oder Differenzialdiagnosen näher eingrenzen zu können. In Bezug auf diverse Infektionserreger ist eine gezielte Blutuntersuchung oft die einzige Möglichkeit einer sicheren Diagnose. Gerade bei Schlangen, die oft wenig klinische Symptome zeigen, ist eine weiterführende Diagnostik wie die Blutuntersuchung unverzichtbar.
Der Originalbeitrag zum Nachlesen:
Leineweber C, Marschang R E. Blutuntersuchungen bei Schlangen.kleintier konkret 2017; 20(S02): 26 - 30. doi:10.1055/s-0043-113660
(JD)
- Campbell TW. Exotic Animal Hematology and Cytology. 4 th ed. Ames, Iowa: John Wiley & Sons; 2015
- Mader DR. Reptile Medicine and Surgery. 2 nd ed. St. Louis, Missouri: Saunders Elsevier; 2006
- Schneller P, Pantchev N. Parasitologie bei Schlangen, Echsen und Schildkröten. 2. Aufl. Frankfurt am Main: Chimaira; 2011



